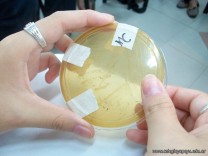

Los alumnos de 6to año, con orientación en Ciencias Naturales, participaron de su primera clase de la cátedra Microbiología, Parasitología Médica e Inmunología, dictada para los alumnos de 2do año de la carrera de Medicina, a cargo del Profesor Titular, Luis Merino, cuyo ayudante de cátedra, es nuestro egresado Germán Arca ’04, quien recientemente aprobó todas las materias de la carrera.
Las actividades se iniciaron con una breve introducción por parte de la Jefa de Trabajos Prácticos, la señora Graciela Patricia Esquivel, quien les informó sobre las generalidades de la materia.
Posteriormente y divididos en comisiones, los alumnos se dirigieron a dos aulas taller, donde se desarrollaba el trabajo práctico sobre diagnóstico bacteriológico. Allí, de a dos, formaron parte de distintos grupos con los alumnos de medicina. Donde tuvieron que observar y describir las diferentes pruebas bioquímicas que permiten identificar bacterias ayudados con la lectura de bibliografía. Finalmente, luego de 2 horas de clase, se dio por terminado el trabajo práctico, donde cada pareja debió realizar la presentación de sus conclusiones para todo el auditorio.
Los alumnos, además de poder trabajar contenidos desarrollados en Biología y Salud, compartieron una jornada con egresados del Colegio, alumnos de distintas provincias, intercambiando sus impresiones, sobre la vida escolar y la universitaria.

Seguí al colegio